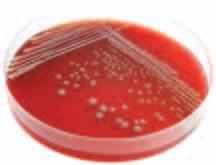

www.onthemindsofmoms.com
PUBLISHER DS Communication, LLC
EDITOR Dani Parkos Fluge
COPY EDITOR Deb Uglem
ADVERTISING Karan Burley Ambuehl p: 701.367.5647
e: karan@onthemindsofmoms.com
Sheri Kleinsasser Stockmoe p: 701.306.1624
e: sheri@onthemindsofmoms.com
PHOTOGRAPHY Ria Czichotzki – rialee photography
Lindsey Johnson – rialee photography
Casie Beldo–rialee photography
Scott Thuen – thuen design
DESIGN AND LAYOUT Scott Thuen – thuen design www.thuendesign.com

AD DESIGN Casie Beldo
Scott Thuen
Tara Kessler
Lindsay Arneson
Stephanie Drietz
EDITORIAL CONTACT e: info@onthemindsofmoms.com
INFORMATION mail: PO Box 190, Fargo, ND 58107
SUBSCRIPTION www.onthemindsofmoms.com/subscribe
COVER PHOTO BY Ria Czichotzki–rialee photography www.rialeephotography.com
OTMOM MISSION STATEMENT
On The Minds Of Moms Magazine is dedicated to providing parents of all ages a bi-monthly resource they can trust. A fresh approach to traditional parenting publications, we are modern and inspiring while offering a community of local support and real-life advice for today’s family.
On The Minds Of Moms contains views from across the parenting spectrum. These views do not necessarily reflect those of the publisher. All activities listed in these pages are at your own risk and require appropriate supervision.
moorhead | mn
Raised in Finely, ND Deb has called Moorhead, MN her home for the last 10 years. Deb has been a stayat-home mom since returning to the Fargo-Moorhead area. She graduated from Drake University in Des Moines, Iowa with a degree in Journalism and Mass Communications. She is excited about her newfound time to write and finds it a welcome distraction to her daily activities. Most daily to-do’s center around her four children’s sport and school activities. Jake [17], Tony [16], Nick [16] and Emily [14] keep both her and husband Tim running in several directions. During her free time you can find her putting in some road miles, spending time with friends, or on the golf course.
dilworth | mn
Patricia Carlson is an award-winning journalist whose work spans magazines, television, radio, newspapers and the internet. She's produced, written, edited and directed programs for ESPN Radio, History Channel and Hallmark Channel. Patricia has worked as a television news reporter and currently is the Sunday morning news anchor at KFGO AM 790. She also is a regular contributor to several magazines based in the Midwest. When she's not writing, Patricia loves spending time with her baby girl and husband. You can view her work at www.patriciacarlsonfreelance.com


moorhead | mn
A counselor at the Rape and Abuse Crisis Center of FargoMoorhead, Sarah primarily works with children and adolescents who’ve experienced abuse. She enjoys hosting parties, being around friends and time spent at the lake with her husband Robby and daughters, Lily Moon [7] and Fiona Eve [4]

fargo | nd
Somewhere between chasing around her 18 month-old son, Grant, the dog, and being a Construction Operations Coordinator for Robert Gibb & Sons; Melissa makes time to treat herself to fashion magazines and shopping trips, whether it is checking out the new style trends for herself, her son or husband, Scott of 4 years. Melissa also enjoys running 5k's with her only sister, Erica, baking anything sweet and delicious and most importantly always making time to be with family.

After the adoption of twin girls, Amy and her husband Dave made the life changing decision for her to be a stay-at-home mom to Taylor [7] , Clare and Isabel [2 ½] Busy with the typical mom activities, she is also a Norwex consultant, the volunteer chairperson of the Catholic Charities Heirloom Quilt Auction and volunteers at Bethany Retirement Living where she takes her girls to visit a family member and other residents.


An assistant professor and program coordinator for the counselor education program at North Dakota State University, Jill has years of experience counseling children, teens, adults, and families in inpatient and outpatient settings. Away from her professional responsibilities you can find Jill spending time with friends, cooking, and working out.

30
percent of kids eat fast food every day

83
percent of African-American children have little to no swimming ability compared to 48% of Caucasian kids Drowning is the 2nd leading cause of death in kids ages 1–14

sources: family circle | center for disease control | parents.com | bitoffun.com
We offer language arts, indoor gym, outdoor play space, science, sensory activities, creative arts, physical fitness activities by Concordia College students, French, Spanish and much more… Come and see our fabulous child care center.

NAEYC accredited



7:00-5:30 (infants-K)
Call Anita 299 -4204 or e -mail brandenb@cord.edu
1306 3rd Street South, Moorhead, MN

Born in Geneva, IL and the oldest of five, Heather Schubbe has a deep love for family and sweet confections Growing up Heather recalls a draw to watching her late mother make all the family birthday cakes, as well as some wedding cakes on the side She was especially attentive to the creation of frosted rose pedals Yet unknown what the future would hold, Heather did know early on she wanted to be “just like mom ” Her journey into motherhood started earlier than expected when her boyfriend [now Fiancé] Aaron first introduced her to his two daughters, Makya [9] and Macinley [13], from a previous relationship While Heather admits being a blended family has its challenges, almost immediately everything felt “just right ” Things were also moving in the right direction professionally when in 2006 she was given the opportunity to manage Mrs Fields in the West Acres Mall – a job she is proud to say she LOVES Tapping into her creative side, she relishes in the challenge of decorating Cookie Cakes for every occasion and all things sweet Today Heather, Aaron, Makya, Macinley and third daughter Kayde [2] enjoy spending time together going to movies, attending Fargo Force games, baking, and scrapbooking Come May, Heather and family will welcome a new member—a son!
 photos: rialee photography | lindsey johnson
photos: rialee photography | lindsey johnson

my interests and hobbies: I love to make cakes! I love going to the Fargo Force! I also like to read, scrapbook, swim, and am on a bowling team every Thursday. my all-time favorite TV family… The Connors from Rosanne. the most fulfilling part of my job… decorating the Cookie Cakes. the habit i hope my kids don’t inherit from me… stubbornness.
the one kid show i can’t stand… Barney.

someone [ past or present, famous or not] i would like to have lunch with…
my mom. She passed away 5 years ago and I miss her dearly. I know my mom, would be so proud of where I am today, especially since I’m doing what she and I both love best…being a great mom and baker.
the last lost object i helped my child find…
her “cuppie” sippy cup and stuffed hippo [she can’t sleep without them]
my most cherished item…
my mom’s jewelry box with her jewelry still in it and her cheese spread recipe.
if i had a $100 in my hand right now i would… get a manicure and pedicure OR a massage.
I’m a sucker for…
chocolate covered peanuts and popcorn, ice cream, and turtle cheesecake.
toughest part of being a blended family is… finding enough time to spend with the girls as little as we have them.

the kitchen accessory i can’t live without… my mixer.
I want my kids to one day experience… being a mother as I have.
I find relaxation in…
reading a “good” book or watching a “good” movie. my best mom meal…
Chicken Cordon Bleu on a bed of wild rice, corn, a baked potato with butter, cheese, and bacon bits, and turtle cheesecake for desert.
in my pantry i always have extra…
Dum Dum suckers [Kayde gets one when she’s good and goes potty on the “big girl potty” ]. My grandpa and grandma always had them when we came to visit too.
Cheyenne's big ideas and big benefits will give you a living space with more possibilities Who's Cheyenne? She is your design solution, her design services are complimentary with the build of your custom Designer Home. She will help you create more liveable space, reduce walls and open up your home for a better flow while adding all the creative touches. Together, you can increase the square footage where YOU want it, with room choices based on your lifestyle. Cheyenne will help you with design decisions from contract to close.






Recurring or chronic pain has many definitions. It can be described as pain lasting longer than three to six months or pain that persists after an injury has healed or a disease is over. Regardless of the definition, living with pain day after day is miserable and too often people focus on managing symptoms rather than finding an underlying reason which may be causing the pain.
You don’t have to live with pain! It is very common to hear people say they have tried various treatment and therapy methods with little to no long-term improvement. This can obviously be very frustrating due to the time, energy and expense they have utilized searching for relief. Many end up feeling they are stuck with the chronic discomfort for the rest of their lives. Who could blame someone for feeling this way?
Well, you have a choice. You can continue with “status quo” or you can say “enough is enough.” A focused rehabilitation program can help you find out what is causing your aches and pains, improve your quality of
life, decrease future healthcare expenses and help you focus on longer-term relief.

The truth is if your joints are not moving well, your muscles are not going to function normally. If your muscles are weak and not functioning properly, you will begin to compensate your movement patterns, muscle imbalances will develop and a chronic pain cycle can result. Without a proper evaluation and a customized rehabilitation program, it is likely this individual will continue on a chronic, recurring pain cycle.
If it isn’t working…try something new! A perfect example of another chronic pain cycle can be associated with being overweight. A recent study stated when people are just 10 pounds overweight, it can place up to 30 pounds of extra stress on the larger weight bearing joints of your body such as your knees, hips and lower back. It’s not surprising that I commonly hear patients say, "I want to get some treatment to decrease the current discomfort I am having and I also want to exercise and lose weight, but each time I exercise it aggravates the pain I am experiencing and therefore I cannot exercise or lose weight."
Just treating the aching knee may never end the pain cycle for the individual in this example. The true cause and the corresponding compensation must be addressed. Rehabilitation targets the cause of a problem to assist people who have recurring pain and discomfort due to past injuries, incorrect movement patterns, poor posture, compensation and muscle imbalances. A professional one-on-one rehabilitation exercise program can truly help many people improve their quality of life, decrease discomfort and allow them to save money instead of spending it on future healthcare.
If your current healthcare provider does not focus upon rehabilitation in their clinic, don’t be afraid to step out of the box, get a second opinion/consult and find out if rehabilitation is the right fit for you. The Red River Valley is full of many fantastic healthcare providers and we are all here to assist you with our specialties.
So, now is the time! A customized rehab program can make sure you know exactly when, why and how to exercise in order to strengthen and stabilize your injured and/or recurring areas of discomfort. A joint is only healthy if it is moving and the muscles are
functioning...correctly. Would it interest you to find out why your chronic discomfort is persisting? Would you like to know which muscles and joints were tight, tender, restricted, overactive, weak and deconditioned? There is no better time than the present to explore other options and make a change.

Are you ready?
300 45th Street South, Suite #315, Fargo www.puredcrehab.com 701.893.7873
Dr. Brad Feldner
Dr. Brad Feldner has over 18 years of chiropractic experience including 10 years of teaching rehab and exercise around the nation. As of February 2011, he is the only Chiropractor in the State of North Dakota who is currently certified in rehabilitation by the ACRB. He lives in Fargo with his wife of 18 years, Laura and their 7-year-old twins, Alexandra and Dylan.


mom and dad: Tara Garland & Ryan Clayton




from: fargo, nd
birthday: july 18, 2008

my favorite eats… Eggo waffles with syrup. I love when they "pop" from the toaster. I'm not a fan of… Halloween—too scary for me. best toy i have… my hockey stick and puck. I am always saying, "let's play hockey!"
I am most like my… Dad—charming, sweet and very witty. I heart… hockey and animals—especially my pups, Jaden, a Collie cross, and Melvis, a Pug.
Michael
mom and dad: Sara & Melvin Whitney from: fargo,nd birthday: may 29, 2009
I love to eat…
Papa and Nana's venison sausage, hot dogs, or chicken nuggets.
I heart… anything sports!
I am most like… my Mom when I clean up my toys and like my Dad when I shout at the TV.


Carly
mom and dad: Tara & Matthew Fee from: west fargo nd birthday: april 9, 2010
I love to eat… yogurt, macaroni and cheese, and cereal puffs. when i was born… my dad helped delivered me.
I am not a fan of… getting my clothes changed or my mommy fixing my hair.




North Central Camp Cherith This Interdenominational Christian camp in Frazee, MN has separate weeks for boys & girls ages 6–18; June 19–August 5. Campers are taught how to make Christ real in every phase of their lives while participating in traditional camp activities, focusing on fun, learning new skills, building friendships & enjoying nature. For more info 612.615.5842, info@camp-cherith.com, www.camp-cherith.com.
Deeper Life Bible Camp
Located in Blackduck, MN our summer camp [ June 19–August 7] is a great place for your kids [1st grade to young adults] to develop relationships that last a lifetime while playing games, singing songs, sitting by the fire & learning about a God who loves them more than they could ever know-at a very affordable price. For more info www.dlbonline. com or contact, contact@lbconline.com.
Camp Joy Bible Camp Near Dent, MN, we offer a peaceful setting with loving staff members helping meet the spiritual, physical & entertainment needs of youth. Camps run June–August with multiple sessions for ages 7–17. Eat Lisa's great food, enjoy Bible time, play sports, participate in the talent show & sit by the campfire. Come meet with God & your friends! For more info www.campjoy.net.
Inspiration Point Christian Camp and Retreat Center
Located on Spitzer Lake, 30 miles southeast of Fergus Falls, Inspiration Point offers a Christian Camping experience with comfortable lodging, excellent food, hospitable staff, reasonable pricing and a wide variety of activities for families and students of all ages. There’s so much more to tell you about, but it would take an entire website to describe it all…hint, hint…www.ipoint.org.
FaHoCha Bible Camp
An interdenominational camp located in Warwick, ND, your days will be filled with fun, great food, new friends, faith lessons and it’s affordable! Multiple sessions offer an opportunity for everyone to attend: Jr. High 1 [ages 12–13] June 3–5—$120, Middler 1 [ages 10–11] June 12–17—$120 Varsity [ages 16–18] June 19–24—$120, Jr. Varsity [ages 14–15] June 26–July 1—$120, Beginner 1 [ages 8–9] July 6–8—$45, Jr. High 2 [ages 12–13] July 10–15—$120, Middler 2 [ages 10–11] July 17–22—$120, Beginner 2 [ages 8–9] July 24–27—$70. For more info 701.658.7548, visit www.fahocha.org, jay@fahocha.org.
ND Fellowship of Christian Athletes Summer Camps FCA Camps are a time of inspiration & perspiration for athletes & coaches! Competitors who want to reach their potential through comprehensive athletic, spiritual & leadership training need to attend an FCA Camp. For more info mouradnik@fca.org, www. fcand.org, www.facebook.com/fcanorthdakota
YMCA Camp Koda This sports & activities day camp is a blast for ages 6–11. Camp is located at the Fercho YMCA in Fargo & runs in weekly sessions June 13–August 19. For more info 701.293.9622, www.ymcacassclay.org/camp. Financial Assistance Is Available!
MSUM Dragon Volleyball Camp The Little Dragon Camp [ July 19, grades K-6] will teach the basic skills of volleyball & team work while having fun learning form the Dragon players & staff! The All Skills Camp [ July 25–27, grades 3–12] is designed for specialized training & skill development. In addition to outstanding instruction, players will participate in 2-on-2, 3-on-3, 4-on-4, & 6-on-6 competitions. For more info katy.peterson@ mnstate.edu, www.msumdragons.com/sports/2008/7/14/ GEN_0714082155.aspx.
Cobber Soccer Camp Located on the beautiful Concordia College campus in Moorhead, we are the largest day & residential camp in the region for soccer players [boys & girls ages 6–18]. Come join our motivated & skilled coaching staff for a fun week of soccer July 11–14. For more info 701.361.8625, weiler@cord.edu, www.cobbersoccercamp.com.
Grover Volleyball Camp The purpose of the camp is to teach basic skills & techniques & work on specialized skills. The fee is $55 for girls grades 9–12; $50 grades 7–8; & $45 grades 4–6. June 13–16 at Oak Grove’s Lutheran School’s north campus [124 N Terrace, Fargo]. www.oakgrovelutheran.com Registration deadline is June 1.
Grover Boys’ & Girls’ Basketball Camp The purpose of the camp is to provide small group instruction on basketball fundamentals as well as promoting wholesome competition. Oak Grove Lutheran School basketball coaches teach basketball as a team sport with cooperation among players paramount. June 20–24 at Oak Grove Lutheran School’s north campus [124 N Terrace, Fargo] , for grades 3–12. Cost is $50 grades 7–12, $40 grades 3–6. www.oakgrovelutheran.com
Grover Football Camp The purpose of the camp is to provide small group instruction on football fundamentals as well as promoting wholesome competition. Registration fee is $50 & is payable upon registration & includes all instructional costs, a camp T-shirt & prizes. July 26–29 for students in grades 9–12. www.oakgrovelutheran.com
VCSU Girls Position Camp Join the Valley City State University Vikings June 12-14 & work on your fundamental skills related to guard & post play. For girls entering grades 5–12, individualized instruction will help refine & improve your skills & footwork. For more info 701.845.7164, jill.devries@vcsu.edu, vikings.vcsu.edu/womensbasketball/camp/
PCS Basketball, Football & Volleyball Camp Held at Park Christian High School, young athletes will learn fundamental skills, teamwork & biblical truth. Basketball sessions will be June 13–16 & 20–23 for grades 1–12. Football will be July 25–28 for grades 7–12 and volleyball will be for grades 4–12 [dates TBD] For more info 218.236.0500, www.parkchristianschool.org.
health
Camp Odayin for Children with Heart Disease For ages 6–17, Camp Odayin in Stillwater, MN provides a day & resident camping experience. Campers discover outdoor, athletic & creative activities in a safe & medically supervised environment. 2011 Sessions—Residential Camp: July 18–22 [ages 14–15] , July 25–29 [ages 16–17] , August 8–12 [ages 8–11] , August 15–19 [ages 11–13]. Day Camp: August 1–5 [ages 6–7]. For more info 651.351.9185, info@campodayin.org, www.campodayin.org.

Missoula Children’s Theatre The Missoula Children’s Theatre presents THE PIED PIPER, an original adaptation of the classic children’s tale. What do you do when your town is overrun by ravenous rats? June 20–25 at Oak Grove Lutheran School’s Scheels Center [124 N Terrace, Fargo] , for students in grades 1-12. Cost is $75.00 & the registration deadline is May 20. www. oakgrovelutheran.com
Courage Center Camps With locations in Maple Lake, MN & Lake George, MN, this summer camp offers a fully accessible, safe camping experience for youth & teens with physical disabilities, sensory impairments or communication disorders. We offer multiple sessions from June–August. Registration deadline is May 20th.For more info 866.520.0504, www.couragecenter. org/camps.


Tamahay Camp for Girls Located on Island Lake [Akeley, MN] , camp is full of adventure – making new friends, appreciating nature, living with others yet growing in independence & individualism. Our campers [ages 7–16] enjoy horseback riding, canoeing, sailing, gymnastics, archery as well as cookouts & overnight camping. Session dates: June 20–July 2 & July 4–16. For more info 218.652.3033, www.tamahay.com.

YMCA Busy Beavers Camp This half-day “camping” experience is designed just for preschoolers, ages 3–5! Camp is located at the Fercho YMCA in Fargo & runs in 4-day sessions June 6–August 18. For more info 701.293.9622, www.ymcacassclay.org/camp. Financial Assistance Is Available!
YMCA Camp Cormorant This resident camp provides kids ages 7–15 with a summer adventure on the shores of Big Cormorant Lake. Spots are filling quickly for weekly sessions running June 12–August 19. For more info 701.364.4116, www. campcormorant.org. Financial Assistance Is Available!
Plane Camp Calling all pilots to-be ages 9–13! Airplane building, introduction to flight, navigation, instrumentation & more are on the agenda at the Fargo Air Museum. Choose an all-day session [ June 10 or July 22] or Morning Session A [ June 10, 17, 24 & July 8,15] or Morning Session B [ July 22, 29 & August 5, 12, 19]. For more info 701.293.8043, www.fargoairmuseum.org.
Camp Invention A summer enrichment program that ignites the imagination. Camp Invention runs from June 6–10 at Oak Grove Lutheran School’s south campus [2720 32nd Ave S, Fargo] The camp is for students in grades 1-6. www.campinvention.org

While we might not want to think about a child being hurt or violated, sexual abuse is a prevalent problem that is often kept silent. According to studies on sexual abuse, as many as one in three girls and one in seven boys will be sexually abused before age 18 [Briere & Eliot, 2003]. And many youth never disclose their sexual abuse.











The information in this article is based on a chapter from our book, Helping Teens Handle Tough Experiences: Strategies to Foster Resilience. The suggestions provided will hopefully heighten your awareness for sexual abuse and aid you in helping a teen that you are concerned

from all types of backgrounds. It may include fondling genitals, masturbation, oral-genital contact, digital penetration, and vaginal and anal intercourse. It is not solely restricted to physical contact and may include exposure, voyeurism, and child pornography [American
has experienced sexual abuse. By providing information to youth and adults on sexual abuse we give people the language they need to explain what may be going on in an unspoken part of their lives.
Sexual abuse is perpetrated upon children from all types of backgrounds and is perpetrated by offenders

Psychological Association]. It’s important to remember that there are touching and non-touching forms of sexual abuse, and neither form of sexual abuse should be minimized.
Perpetrators of sexual abuse use power and control over the victim. While most sexual abuse is perpetrated by adults, it can also be perpetrated by other minors,
sexual abuse can impact a person’s core beliefs about himself and the world; some teens work to create a façade so no one knows how horrible they feel inside
such as in cases of date/acquaintance rape and sibling incest. The emotional trauma which results from the type[s] of abuse perpetrated varies from youth to youth.
Becoming aware of the warning signs for sexual abuse is a powerful tool. The presence of one warning sign does not mean a teen is being sexually abused and in fact, some who are being sexually abused exhibit no warning signs. But you should become concerned if warning signs appear over a period of time and/or multiple signs are present:

• withdrawal from family, friends, and activities
• anger/aggression toward family members, friends, or pets
• running away
• lack of trust
• advanced or unusual sexual knowledge and/or behavior for youth’s age
• nightmares
• sudden refusal to change clothes in the locker room or engage in physical activities
• sudden change in appetite and/or weight
• becomes pregnant or contracts a STD/STI at an early age

• depression and/or anxiety
• suicidal ideation or attempts
• self harm, such as cutting or burning
• unusual fears [e.g., fear of certain locations]
• low self-esteem
• increase in somatic complaints, such as headaches


Signs of sexual abuse vary from teen to teen, the list we provided of warning signs focuses on the less socially acceptable ways teens cope with sexual abuse, but we must not dismiss teens who employ more socially appropriate coping skills, such as becoming an overachiever. Sexual abuse can impact a person’s core beliefs about himself and the world; some teens work to create a façade so no one knows how horrible they feel inside.
The recommendations here are general guidelines for anyone who suspects sexual abuse.
Contact your local Child Protective Services or law enforcement and file a report. Remember that it’s not your responsibility to investigate your concerns of sexual abuse, but it is your responsibility to report your concerns.

• don’t force a disclosure As difficult as this may be, let the teen determine when to disclose sexual abuse. Ask direct questions about your concerns with plenty of time for the adolescent to talk. Be clear, direct, non-judgmental, and gentle with your concerns, and give examples of why you are concerned. Enter into the conversation without a predetermined outcome: don’t assume the teen will disclose.
• be calm If you suspect your child has been sexually abused, refrain from exhibiting your anger/disgust/ panic around them. Staying calm, being supportive, and maintaining a non-judgmental stance are some of the most important things you can do to support someone who has been sexually abused. When a teen discloses sexual abuse to a parent, that parent’s reaction is one of the most predictive elements of how the teen will cope with the trauma throughout his life.
If a teen has been sexually abused, it is important to provide support and help within the following guidelines:
• allow the teen to lead We may feel compelled to ask a teen all of the questions we have, but that may be more to meet our own emotional needs than your teens. Refrain from asking too many questions, but tell them that you are there to listen when they’re ready to talk. It is courageous for a teen to disclose abuse and to talk about how it is impacting them; let your teen know how strong he/she is.
• believe what they say Children almost never lie about sexual abuse. Even if it feels horrible to wrap your mind around about what has happened to your child…believe what you are being told!

• assure the child this is not their fault While it may seem obvious to us that a person never deserves abuse, many victims of abuse believe they are to blame. Through persuasion by the abuser and/or messages we receive about abuse through media and culture, teens often believe they brought the

abuse upon themselves. Assure the child they are not to blame and nothing they ever did is the cause of sexual abuse. State as often as needed that abuse is a choice made by the abuser.
• do not blame the victim We receive many victimblaming messages in our society, such as the myth
and be responsible for their own behavior. No one causes sexual abuse but perpetrators!
that girls who dress and act in a provocative manner are asking for the sexual attention of older men. Challenge yourself to explore any beliefs you are holding about a teen inviting sexual abuse. Do you believe a teen could cause sexual abuse through their dress or behavior? Do you believe teens should accept some responsibility for sexual abuse? Members of our society are expected to control
• seek counseling Individual and group counseling services are available to children and adults who have experienced sexual abuse at Rape and Abuse Crisis Center [RACC]. Victims of abuse and their non-offending parents are encouraged to call 701.293.7273 to set up services.
• don’t make promises you can’t keep While this may seem simple enough, the pain of hearing a teen share they are being or have been sexually abused will naturally lend itself to us wanting to ensure it never happens again. Be careful to avoid statements like, “I will make sure this never happens to you

Get fit, feel better. Try Whole Body Vibration and train more muscles in 10 minutes than most workouts do in 60.
Get fit, feel better. Try Whole Body Vibration and train more muscles in 10 minutes than most workouts do in 60.
Tired of chronic pain and discomfort returning? Our customized rehab programs can treat the cause, not just the symptom.
Tired of chronic pain and discomfort returning? Our customized rehab programs can treat the cause, not just the symptom.
while it may seem obvious to us that a person never deserves abuse, many victims of abuse believe they are to blame


again.” You can play a powerful role in helping a teen who has been sexually abused, but you cannot guarantee perfect results in a sexual abuse case. Hopefully the information we’ve provided here will encourage you to break the silence about sexual abuse and equip you with some tools to utilize if sexual abuse has impacted a child in your life.

recommended resources
• All materials by Toni Cavanagh Johnson, Ph.D. Her books and pamphlets can be ordered from her website, www.tcajohn.com.
• National Child Traumatic Stress Network [www. nctsnet.org ]. Provides resources and information for parents, caregivers, educators, and professionals on child traumatic stress.
• National Sexual Assault Hotline: 1-800-656-HOPE. Free, confidential, available 24 hours a day.
• RAINN: Rape, Abuse and Incest National Network [www.rainn.org ]
references
American Psychological Association Online. (n.d.) Understanding child sexual abuse: education, prevention, and recovery. Retrieved February 22, 2011, from http://www.apa.org/ pubs/info/brochures/sex-abuse.aspx
Briere, J., and Eliot, D.M. (2003). Prevalence and Psychological Sequence of Self-Reported Childhood Physical and Sexual Abuse in General Population: Child Abuse and Neglect, 27(10).
Indicators of child sexual abuse. Handout by the Rape and Abuse Crisis Center of Fargo/Moorhead.
Nelson, J. R. & Kjos, S. (2008). Helping Teens Handle Tough Experiences: Strategies to Foster Resilience, Search Institute, Minneapolis, Minnesota. https://www.searchinstitutestore.org/ Helping_Teens_Handle_Tough_Experiences_p/0324-w.htm
Reprinted with permission from Helping Teens Handle Tough Experiences: Strategies to Foster Resilience, by Jill Nelson and Sarah Kjos. Copyright © 2008 by Search Institute, Minneapolis, Minnesota, 800.888.7828, www.search-institute.org. All rights reserved.


www.stopchildabusend.com
www.pcamn.org
Help strengthen families and prevent child abuse and neglect.
4
Are
701.234.7233
www.north.sanfordhealth.org
Did you know that 80% of children are riding incorrectly. This class will give you the education to correctly use and install a car seat, as well as learn about child passenger safety laws, airbags & bus safety. Make an appointment be at the Sanford Auditorium [801 Broadway North, Fargo] between 6:00pm–9:30pm. Space is limited & pre-registration required. $30 fee.
6 & 14
Bird Brains
701.277.9240
www.redriverzoo.org
From chickens to eagles, and “Stan”, our crane, get ready to explore life in flight as we talk about the different birds found at the Red River Zoo. For ages 4–6 at 10:00am on April 6th or 2:00pm on April 14th.
7 & 8
Notching Up Success
701.241.5700
www.ag.ndsu.edu/
casscountyextension/home-and-family
Notching Up Success with the Nurtured Heart Approach is for parents and professionals who are using the approach in daily practice. Featuring Lisa Bravo, MC, LPC, LISAC, NCC, founder of ParentWoRx Consulting, coauthor of Transforming the Difficult Child Workbook and proud mother of two wonderful teens. April 7th offers a FREE Parents Night 7:00pm at the Ramada Plaza Suites and the 8th features a Full Day Professional Conference.

9
Parents' Fair
http://childrens.sanfordhealth.org
Join Sanford Health at the Hilton Garden Inn, Fargo for one of the region's most valued events geared towards raising healthy kids.
11
701.241.5700
www.ag.ndsu.edu/ casscountyextension/home-and-family
Love & Logic teaches empathy, respect and offers choices to children. Adults, in turn, learn how to avoid anger, threats, warnings & lectures. Gain ideas to help cultivate confidence and good decision making in your children. Classes held at YMCA Downtown April 11 & 18; May 2, 9, 16 & 23. Plan to attend all classes in session. $15 fee.
12
Puppy Treats
701.476.5978
www.fargolibrary.org
Teens [ages 11-18] can learn to make homemade treats for their favorite, fourlegged, furry friends at the Dr. James Carlson Library [2801 32nd Ave S, Fargo]. Space is limited; pre-registration is required.
14
Parents
701.234.7233
www.north.sanford.org
Are your car seats installed correctly? Don't take the chance! This class is designed for expectant parents and focuses on infant car seats for newborns. Make an appointment be at the Sanford Auditorium [801 Broadway North, Fargo] between 6:30pm–8:00pm. Space is limited. Preregistration is necessary.
16
Parents Forever
701.241.5700
www.ag.ndsu.edu/
casscountyextension/home-and-family
Parents Forever is a comprehensive educational program that puts parents on the path to minimizing stress for themselves and their children. Designed to help parents through the process of making informed, child-supportive decisions during separation and divorce, resulting in healthy children and positive parent-child relationships, information will be covered over three classes on April 16th, May 10th & June 14th. Class fee applies.
16
Awesome Art Afternoon
701.241.8160
www.fargoparks.com
Love art but hate the mess? Bring your child to RDJ Rec Center [1104 2nd Ave S, Fargo] , 1:00pm–3:00pm, to have fun while building a variety of take home projects. This is a FREE event.
17
Unraveled Crafters
701.476.5977
www.fargolibrary.org
All interested crafters are invited to the Dr. James Carlson Library [2801 32nd Ave S, Fargo] , 1:00–3:00pm, for some unraveled fun! If you are new to knitting or crocheting, they'll teach you!
19
Keeping Your Kids Out of the Crossfire
701.241.5700
www.ag.ndsu.edu/
casscountyextension/home-and-family
This 2-hour workshop [6:00pm–8:00pm at the West Fargo High School] is for parents who are experiencing separation or divorce or who have attended the Parents Forever class. How to recognize



and prevent negative effects of divorce, custody battles and parent adversity on your children will be discussed. Cost is $10. For more informations, visit website or email diane.langer@ndsu.edu.
19
Hunt for Easter eggs in the dark at Veterans Memorial Arena! Kiddo [ages 2–8] can meet the Easter Bunny, decorate Easter eggs, take part in crafts, decorate a cookie & play on inflatable games 5:00pm-7:00pm. $3 per participant & concessions will be available for a minimal charge.
19
Minute 2 Win It: Library Edition
701.476.5978
www.fargolibrary.org
Teens, [ages 11–18] , are invited to compete in a series of events similar to the popular game show at the Dr. James Carlson Library [2801 32nd Ave S, Fargo]. The fun starts at 4:00pm. Pre-registration is required.
20
Create Comics
218.233.7594
www.lalr.org
Head to the Morhead Library [118 5th St S, Moorhead] and create some comics with Blake Hoena! This FREE event starts at 7:00pm.
22 & 23
Easter Eggstravaganza
701.232.6102
www.childrensmuseum-yunker.org

Get your "Boots & Bonnet's" for a day full of family fun at Yunker Farm. Explore, discover, & create Eggciting spring projects, dye Eggs, visit the Easter Bunny. Join the Eggcelent Egg Hunts at 11:00am, 1:00pm, & 3:00pm. $4 admission per person [Members free]
Kids Are Our Business Breakfast
701.293.7273
www.raccfm.com
Join the Rape and Abuse Crisis Center for breakfast at the Holiday Inn at 7:30am & help out a great cause. Seating is limited so call today! Cost: $65 individual tickets. Table & Event Sponsorships Available. Pre-registration encouraged.
30
March for Babies
701.235.5530
www.marchofdimes. com/northdakota
Join the March of Dimes at the Veterans Memorial Arena [1201 7th Ave E, West Fargo] for the March for Babies. Warm up begins at 9:00am with the march starting at 10:00am. The money raised will support lifesaving research, community services, education and advocacy that help babies get a healthy start.
30
Garden Party
701.241.8160
www.fargoparks.com
Kids & parents, get in the gardening mood at this pre-summer FREE event at Rheault Farm [2902 25 St S, Fargo] , 1:30pm–4:30pm. Enjoy creating take home insect arts & crafts. There will also be a bug hunt, face painting, plant walk, and more! Red River Zoo animals and Don Carey the Bug Man provide entertainment!

Parade of Homes
www.hbafm.com
Checkout some of the beautiful homes available to tour noon-5:00pm weekends and 6:30pm–8:30pm weekdays.
5
www.areafoundation.org
Bring your girlfriends to Northern Home Funiture and Design [505 N Broadway] & enjoy an evening of wine and hors d’oeuvres while bidding on fabulous silent auction items. Tickets are $40 & all proceeds support the work of the Women’s Fund Endowment, a permanent component of the FM Area Foundation. The Women’s Fund Endowment awards grants each year to area non-profits that support three areas of focus: children in the need of care, economic well-being of women and their families, & opportunities for women in leadership.
5
701.526.1565
www.halfachild.com
Come join us at the Hilton Garden Inn [ 4351 17th Ave S, Fargo] as we showcase children’s mental health resources in our community by more than 20 agencies/ groups at the fair. Suzette Scheele [National Alliance on Mental Illness] will provide information on warning signs, how to talk with parents about concerns and strategies for improving behaviors in children. The fair is open to the public 4:30pm–7:30pm & training is 6:00pm–8:30pm. $10 fee.
7
Youth Journeys
800.237.4629
www.hrrv.org
Youth Journeys is a program for young people, ages 6-18, who have lost a loved one through death. Adults are encouraged to accompany children. The class will held at Hospice of the Red River Valley [1701 38th St S, Fargo] 9:00am–4:00pm. Registration is required by May 2nd. For for information or to register, contact the Journeys Department at 800.237.4629.
701.364.1704
www.fmambulance.com
The initial course for teens and pre-teens on the responsibilities of caring for children. They will learn CPR and first aid for children, as well as diaper changing techniques, also learn about when to call 911 and what will happen if they do need emergency assistance. The course is designed for young babysitters ages 11–15. Limited space. Register online.
7 Kite Day
701.241.8160
www.fargoparks.com
Come show off your kite flying skills at Ed Klapp Park [2801 32nd Ave S, Fargo] 12:30pm-3:00pm. Prizes will be given to winners in youth and adult categories.
8
Unraveled Crafters
701.476.5977
www.fargolibrary.org
All interested crafters are invited to the Dr. James Carlson Library [2801 32nd Ave S, Fargo] , 1:00–3:00pm, for some unraveled fun! If you are new to knitting or crocheting, they'll teach you!
8
Spring Concert
Come to the Trinity Lutheran Church [210 7th St. S., Moorhead] for the Lake Agassiz Girls Chior 20th Anniversary Spring Concert. Silent Auction starts at 6:00pm followed by the concert at 7:00pm. Tickets are $10 for adults & children under 12 are $5.
8
YMCA Breast Cancer Walk
www.fmbreastcancerwalk.org
Three mile walk beginning & ending at West Acres to raise funds for breast cancer research & help find a cure.
9
11, 18 & 25
19
Are your Kids Riding Safely?
701.234.7233
www.north.sanfordhealth.org
Did you know that 80% of children are riding incorrectly. This class will give you the education to correctly use and install a car seat, as well as learn about child passenger safety laws, airbags & bus safety. Make an appointment be at the Sanford Auditorium [801 Broadway North, Fargo] between 6:00pm–9:30pm. Space is limited & pre-registration required. $30 fee.
11
Every Stitch Tells a Story
www.catholiccharitiesnd.org
The Catholic Charities Heirloom Quilt Auction at the Fargo Country Club will help benefit Pregnancy, Parenting & Adoption Services of their agency. The event will feature machine or hand-quilted heirloom quality quilts made by local quilters in live and silent auctions.
Community Block Party
701.241.8160
www.fargoparks.com
Meet your neighbors at this fun family event 5:30–8:00pm. Sing your favorite karaoke song, play on inflatable games, take home a craft project and get your face painted. Enjoy free food while supplies last. May 11th @ Lindenwood Park [1701 5 Ss S, Fargo] , May 18th @ Jefferson Park [315 16 St S, Fargo] & May 25th @ Roosevelt Park [1220 9th St N, Fargo]
19

Nature Adventure
701.241.8160
www.fargoparks.com

Bring the family out for a fun evening outdoors at the Lindenwood Rotary Shelter [1701 5th St S, Fargo] , 6:00pm–8:30pm. This is a FREE event with hands-on cooking, crafts, games & nature activities.
701.234.7233
www.north.sanford.org
Are your car seats installed correctly? Don't take the chance! This class is designed for expectant parents and focuses on infant car seats for newborns. Make an appointment be at the Sanford Auditorium [801 Broadway North, Fargo] between 6:30pm–8:00pm. Space is limited. Preregistration is necessary.
www.fargomarathon.com
This year you can Run Fargo & Rock Fargo at the 2011 Fargo Marathon! Known by thousands for being one of the Fastest & Friendliest races on the calendar, they’ve added a Fun twist….Fargo Rocks! Bands at EVERY mile & a post race concert are part of mix.
1, 8, 15, 22 & 29
Community Block Party
701.241.8160
www.fargoparks.com
Meet your neighbors at this fun family event 5:30pm–8:00pm. Sing your favorite karaoke song, play on inflatable games, take home a craft project and get your face painted. Enjoy free food while supplies last. June 1st @ Bennett Park [1900 58th Ave S, Fargo] , June 8th @ Village West Park [4415 9th Ave Circle S, Fargo] & June 15th @ Madison Park [3010 11th Ave N, Fargo] , June 22nd @ Rheualt Farm [2902 25th St S, Fargo] & June 29th @ Courts Plus [3491 S University Dr, Fargo]
4
Share a Story
701.241.8160
www.fargoparks.com
Come to Rheualt Farm [2902 25th St S, Fargo] , 10:30am–4:00pm & see Dr. Suess's The Cat in the Hat! Enjoy stories shared through music, dance and performances by community members. Free books, free food and free admission!
6
8
11
www.innovishealth.com// Services/WomensChildrens
This one-time evening class is designed for 'dads to be'. An experienced dad leads the class. Topics discussed include adjustments to fatherhood, what to expect from a newborn baby & how to support mom during this time. Class is from 6:30pm–8:00pm, register online.
7, 14, 21 & 28 Park It!
701.241.8160
www.fargoparks.com
Meet the Xcellent Art teacher at the park & create take home arts & crafts 1:00pm4:00pm. This is a FREE event. June 7th @ Elephant Park [100 19th Ave N, Fargo] , June 14th @ Clara Barton Park [1451 6 St S, Fargo] , June 21st @ Trollwood Park [3664 Elm St N, Fargo] & June 28th @ Madison Park [3010 11th Ave N, Fargo]
Family Fun
218.284.3400
https://communityed. moorhead.k12.mn.us


Bring us your moms, your dads, your grandparents, your infants, toddlers & preschoolers! We will enjoy our time together in theme-related activities, play and learning. Young children learn best by exploring materials firsthand. Class meets every Wednesday 9:00am–11:00am through June 22nd.
8–12
RibFest 2011
www.fargoribfest.com
Great food, live entertainment & fun for the whole family. Riblet Fest for the kiddos offers free admission from 11:00am-2:00pm June 11th.
The Jack Attack on SMA
www.fsma.org/jackattack
Head to Lindenwood Park for Round 7 of The Jack Attack & help us develop a treatment & cure for Spinal Muscular Atrophy! Registration begins at 9:00am with the walk starting at 10:00am. Remember, we walk RAIN or SHINE! 100% of proceeds raised go directly to help find a treatment or cure for SMA. Together we will "KNOCKOUT SMA!"
11 & 12
Grand Cities Art Fest 701.772.3710
www.novac.org
The Annual Grand Cities Art Fest is once again being held in the downtown areas of Grand Forks & East Grand Forks. Over 130 local, regional and national artists will be displaying their works on Saturday 10:00am–6:00pm & Sunday 11:00am–5:00pm. Food vendors will also be selling mouthwatering items such as hot fresh-cut fries, pulled pork sandwiches, corn dogs, kettle corn, Italian Ice & cold lemonade. Each day there will be shows on the performance stage in East Grand Forks and Town Square in Grand Forks.
13
Rumble in the Jungle
218.284.3400
https://communityed. moorhead.k12.mn.us

We are thinking of fun! Imagine activities & learning about giraffes, elephants, big cats & monkeys. Can you feel the jungle beat? For ages 2 1/2 to kindergarten. Class meets three times 9:30am–11:30am.
16
Parents
701.234.7233
www.north.sanford.org
Are your car seats installed correctly? Don't take the chance! This class is designed for expectant parents and focuses on infant car seats for newborns. Make an appointment be at the Sanford Auditorium [801 Broadway North, Fargo] between 6:30pm–8:00pm. Space is limited. Preregistration is necessary.
17
Midwest Kid Fest & Teddy Bear Parade

701.241.8160
www.fargoparks.com
Island Park [302 7th St S, Fargo] will be filled with music, laughter & bright colors
11:00am–7:00pm as children play & learn. Bring a teddy bear to the Dike West Parking Lot and begin the day with a march in the parade starting at 10:30am. All activities are free!
Scandanavian Hjemkomst Festival
218.299.5452
www.nordiccultureclubs.org
Celebrate all things Scandanavian at the 34th annual Scandanavian Festival at the Hjemkomst Center [202 1st Ave N, Moorhead] , 10:00am–5:30pm. $10 for adults, 18 & under free.
27 Movie Night
701.241.8160
www.fargoparks.com
Come to Island Park [302 7th St S, Fargo] at dusk for some fun in the park at the annual Summer Movie Nights! Free Pepsi & popcorn while supplies last.
All event listings displayed within OTMOM are carefully selected to provide diverse options for families. It is always a good idea to call ahead to confirm the information provided. Although it is not possible to list every event happening in the FM area it is encouraged organizations submit events for consideration to info@onthemindsofmoms.com
Originally from rural Grafton, ND and the youngest of four children [one sister and two brothers] Nora Bartram [51] grew up on a potato farm where she says “a meal just wasn’t complete without some sort of potato for a side dish—a potato in any form is still my ultimate comfort food ” After graduating from high school she left the farm for the “big city” of Fargo where she attended NDSU and earned an Early Childhood Education and Family Science degree For several years following Nora worked for the FM YMCA in their Childcare Center, until she and husband Kevin of 28 years, welcomed Kyle [23] and Katie [20] allowing her the opportunity to be a stay-at-home mom until both kids were in school Finding her feet again, Nora began exploring the world of interior design as a part-time volunteer at Northern Home Furniture & Design—a then small store that opened under her husband’s architectural firm Over time Nora grew into the owner role and today is fully involved in the business on a daily basis Away from the office you can find Nora serving on the NDSU Memorial Union Advisory Board and the Women’s Fund Advisory Committee—chairing their signature fundraiser, “Philanthropy by Design”
 photos: rialee photography | casie beldo
photos: rialee photography | casie beldo
what was the inspiration to open a furniture store?
Northern Home Furniture grew from the increasing residential work the interior design team in her husband’s architectural firm was experiencing. It started small with only a few groups of furniture in their old office space, then it expanded to a showroom at 300 NP Avenue., and has now grown into the beautiful open showroom in the Historic Ford Building.
how many employees do you have?
We have 5 designers, 2 delivery / warehouse people and myself.
how long has NHF been in business?
We will celebrate our 10th Anniversary this fall. do you work with commercial or residential customers?
We work primarily with residential clients, but welcome commercial clients as well.

what is your primary role at NHF?
I handle all the ordering, marketing, customer service issues and coordinate special events that we host. I also accompany Sheila, our design manager, to market to choose the furniture and accessories for the showroom.
what quality do you believe every woman needs to have to be successful in business? She needs to love what she is doing and believe in herself.
what experience did you rely on when planning your business?
I really didn’t have any experience in running a business so I had to learn with “on the job training.” Certainly my background in teaching, many life experiences and time spent in volunteer opportunities provided valuable knowledge. Just knowing how to work with others is very important.
what is the biggest misconception of your business?
Many do not know that we carry a wide variety of furniture styles and price points. We also have many accessories, dishes and glassware.
what business knowledge do you have now that you wish you had when starting out?
I wish I had known more about marketing a business in the beginning.
what is the best kept secret of Northern Home Furniture that we may not know about?
We are not only a furniture store. We have interior designers that can help with any and all aspects
of your home project, including space planning, flooring, tile, and kitchen and bathroom design. We can partner with our architectural firm if the project calls for it. We are truly “full service.” We love projects of all sizes - anything from finding that perfect accessory to helping with your entire home design. if you could do any part of your business over again, what would it be?
I would have opened the store on Broadway right away. When we were on NP Avenue we were strictly a destination for shoppers—they had to be looking for us, but since being on Broadway, our walk-in traffic has increased and so have our sales. Location, location, location!
what is your biggest productivity secret that helps you accomplish the most in your day?
I am a list person. Taking the time to make a list and prioritize the things that need to be done keeps me on track. I have also learned that when the demands of the business are getting to me, it is OK to step away for a few minutes, take a walk, and gather my






catalystmedicalcenter.com
COUGH, SNIFFLE, SNEEZE
Allergies affect children at school, in extracurricular activities, at home and during sleep. The most common allergies are to:

1. Pollens (outdoor)
• Springtime = hay fever from trees & grasses
2. Household allergens (present year round)
• House dust
• Pet danders
• Chemicals
3. Mold (present year round & outdoors/indoors)
4. Food
Our physicians are moms and know the importance of keeping kids healthy and happy!
Call 365.8700 to schedule an allergy consult today.

thoughts. After a short break, suddenly the task at hand seems so much easier to deal with. Spending a few minutes away saves time in the long run.
outside of your profession what might we find you doing?
I love to bake, read, travel and spend time with family and friends. My husband has a Harley and we enjoy going on weekend rides—or try to arrange a few group rides each year with friends.
how has your family benefited from you owning your own business?
I have become a better wife and mother because I have been happier and more self confident.
what has been the most rewarding part of being a mompreneur?

The MOM part, of course!
would you encourage your children to own their own business?

Certainly, but only if they have a passion to. I want them to follow their dreams and will be there to support and cheer them on.
what lessons do you hope your children have learned watching you be a mompreneur?
That it is important to work hard, respect others and believe.
what is the best advice you would share with a budding mompreneur?
It probably won’t be easy, and there will be long hours and lots of responsibility, but if being a mompreneur is what you truly want to do, you should try. Do the research first, make educated choices, and most importantly, believe in yourself!
Northern Home Furniture & Design

505 N Broadway, Fargo, ND 58102
701-271-1550
www.northernhomefargo.com



Monday – Friday 10am–6pm Saturday 10am–4pm

story by | march of dimes—north dakota chapter
In 1938, during the Great Depression, President Franklin Delano Roosevelt had a weekly radio show aimed at motivating Americans to move forward. During one of these shows, he recommended Americans think of their “future”—and that future was our children, who were being taken away by polio. FDR challenged Americans to respond to this killer disease by sending “their spare dimes” to the White House, and he’d do his best to conquer polio. Americans responded by “marching” over 2 million dimes to the White House. The name March of Dimes [MOD] was born and 20 years later, polio was conquered! Rather than simply locking the doors and turning out the lights, the March of Dimes turned its focus to babies.
how many babies/families locally benefit from the MOD?
Today the mission of the March of Dimes is to improve the health of babies by reducing birth defects, prematurity and infant mortality. In North Dakota, one in nine babies is born premature. Of the approximant 9,000 babies born each year in our state, over 1,000 are born premature, which translates to almost twenty babies per week! Of those twenty premature babies, nine will have lifelong health issues such as blindness, mental retardation, cerebral palsy and other heart/lung issues, and one will die.
The March of Dimes has successfully funded and lobbied for newborn screening including PKU testing as well as 29 inherited disorders in North Dakota—some
of which can be avoided and treated when detected in time. We also fund neonatal intensive care units [NICU’s] as well as much of the equipment found in them. Because of research funding of things such as sonograms, ultra-sounds, nitric oxide therapy, surfactant therapy, incubators, sickle cell anemia, Fetal Alcohol Syndrome and folic acid benefits—if you know a baby, had a baby, or have been a baby, the March of Dimes has touched you!
when a baby is born premature or sick, how does the MOD step in?
The March of Dimes offers information on prematurity as well as an online community called Share Your Story [www.shareyourstory.org ] where you can find comfort, support and information from others who understand the challenges and uncertainties of the NICU experience. Additionally, we provide NICU Family Support programs in hospitals nationwide. Essentia Health houses this family-centered program in North Dakota, which provides information, comfort, and support to families as they enter the overwhelming experience of a NICU journey. We are there during their extended stay, as they transition to home or in the event of infant death.
how are the funds raised by MOD distributed?
The March of Dimes uses 75.4% of money raised for program services:

• 37.2% provides public and professional education
• 14.5% goes to research/medical support
• 23.7% provides community services
Locally, 70% of the dollars raised in North Dakota stay in North Dakota! Other than monetary donations, people can also get involved by joining our advocacy network, volunteering for events or office assistance, or by joining our Program Services Committee to assist in spreading the word of prenatal care.


what is the biggest hurdle MOD ND faces?
Like many nonprofits these days, the March of Dimes is volunteer lead and driven and assist us in meeting our goals and objectives. Unlike other organizations, we receive zero support from government agencies. Getting our name out there, making people aware of our mission so we can do for prematurity what we did for polio, is our biggest hurdle. We are “ground zero” of the healthcare process by wanting a healthy start for babies and their families. Consider attending:

March for Babies—April 30th @ 9am, West Fargo Veterans Memorial Arena The year’s largest fundraiser, businesses and individuals sign up as walkers, form teams [from 1–600], raise money by seeking pledges to raise funds and awareness of the MOD mission. They come to the event, turn in their donations and walk for one hour to signify the 54 babies born each hour in the US. Afterwards, we eat, celebrate the top teams & walkers, honor all babies and pay tribute to those that passed on.

The Signature Chefs Auction—September 27th @ 5:30–9pm, Ramada “The Black Bib Affair” is a black tie event gala that showcases the top chefs from the area. Diners are invited to enjoy an evening of food sampling, wine and beverages. A silent auction is followed by a live auction that provides “personal experiences” provided by these Signature Chefs.
Bowls for Babies—December 7th @ 11am–1:30pm, Ramada Local business and artists [students, art teachers & artists] design and paint pottery and ceramic bowls displayed at the event and upscale restaurants donate their favorite soups. Patrons select a bowl to keep as a souvenir of their support and enjoy the variety of delicious soups & breads available. This year, in lieu of a silent auction, a very large quantity of diverse raffle items will be available. Event tickets are $20 and include admission and two raffle tickets. Tickets are available at any Gate City Bank starting the day after Thanksgiving or at the door the day of the event.
You’ve decided. You’ve planned. You’re excited to hear a little voice say mama or dada. You’ve tried to get pregnant, but it’s just not as easy as you thought.
As the only comprehensive reproductive medicine program in North Dakota, Steffen Christensen, MD, Stephanie Dahl, MD and Erin Lee, NP are here to help you conceive.


When you’re ready for baby, we’re ready for you.

When you’re ready for baby,Steffen Christensen, MD Stephanie Dahl, MD Erin Lee, NP
Straight from the kitchen of Mosaic Foods, fish tacos are becoming popular all over the country for their light, yet zesty flavor. Local chief, wife and mother of four, Sara Watson shares this lower calorie option you can easily make at home topped with flavorful slaws and salsas—fish tacos are a perfect alternative to their traditional beef counterpart.
 photo: thuen design | scott thuen
photo: thuen design | scott thuen
fish tacos serves 4
• 1 pound white flaky fish such as mahi mahi, snapper or grouper
• 1 lime, juiced
• 1 tsp cumin
• 1 tbsp ancho chili powder
• 1/8 tsp salt
• 1/8 tsp garlic powder
• 1 jalapeno chopped
• ¼ cup fresh cilantro leaves
• 8 flour tortillas
Preheat oven to 425 degrees Mix Lime, cumin, ancho chili powder, salt, garlic powder, jalapeno & cilantro to form a spice rub Place your fish fillets in a baking dish and rub with spice mixture Let stand for about 15 minutes to allow the fillets to absorb some the flavor Place fish in hot oven for about 10 minutes, or until cooked through Quickly place tortillas in oven to heat up slightly Break apart the fish and place in tortillas
Garnish with your choice of nappa cabbage mix, salsa, guacamole, sour cream & hot sauce

nappa cabbage slaw
• 1 small head Nappa Cabbage, shaved
• ¼ cup fresh cilantro leaves, chopped
• 1/8 cup diced red onion
• 2 tbsp oil
• 2 tbsp lime juice
• Salt and pepper to taste
Mix all ingredients, let sit 1 hour before serving to allow seasonings to mix
fresh tomato salsa
• 2 tbsp canola oil
• 3 cloves garlic, chopped
• 4 large ripe tomatoes, chopped
• 1 jalapeno chile, sliced
• 1 serrano chile, sliced
• 1 tbsp oregano
• ¼ cup chopped cilantro leaves
• 1 tsp red wine vinegar
• 1 tbsp lime juice
• Salt and pepper to taste
Heat oil in medium saucepan, add onions and garlic and cook until soft Add the tomatoes and chiles and cook until soft Puree the mixture with a blender or hand-held immersion blender until smooth Cook for another 15 minutes Add the oregano, cilantro, lime juice and vinegar Season with salt and pepper to taste
guacamole
• 2 avocado’s diced
• 1 jalapeno, diced
• 2 tbsp red onion, diced
• 3 tbsp fresh cilantro leaves
• 3 tbsp lime juice
• Optional: ¼ cup sour cream or greek yogurt


• Salt and pepper to taste
Mix all ingredients together and let sit for 1 hour before serving

2 1/2 pounds potatoes
4 cloves garlic, sliced 2/3 cup plain unflavored soymilk
2 tablespoons butter 1/2 teaspoon salt 1/4 teaspoon pepper
Place potatoes and garlic in a saucepan; cover with water. Bring to a boil over medium heat, reduce heat and simmer 30 minutes or until potatoes are tender Drain. Add soymilk, butter, salt and pepper. Beat with an electric mixer until smooth. Yield: 6 servings.
Atrue farm boy at heart, Tom Frappier grew up in central North Dakota the second oldest of five brothers and a sister [the baby of the family] After high school, Tom went on to study agronomy at NDSU and while in graduate school met his wife Nicki, of 27 years, a Concordia College basketball player and alum Recently Tom completed his 29th year with Pioneer Hi-Bred as an Agriculture Account Manager where he spends his days providing support to a small group of sales reps— both on the crop production and sale of corn, soybean, sunflower and alfalfa seed to farmers Tom enjoys time with his wife and sports-minded family, Kayla [24] and Zach [22] , playing basketball, baseball, football, golf or simply going out for walks or runs—staying active, having fun and being healthy is a Frappier family motto
 photos: rialee photography | casie beldo
photos: rialee photography | casie beldo
I raised my kids to always… be respectful of others.
the one parent regret i have…

I wish we would have traveled more with the kids when they were younger. All their school activities really filled the calendar as they got older. in ten years i can see myself… wrapping up a good work career and having time to do some of the things we wish we could do more now. We’d love to travel more, spend time outdoors, hang-out with good friends, including our own kids and maybe even their families.
the one gadget i can’t live without…
I’m not going to say my cell phone even though it’s pretty valuable but don’t take away my Astro-Start!!

the toughest age to parent… this is where my fuzzy memory works great but I don’t remember our kids really being that difficult. I do remember some grocery store discussions about what the word “no”

means when they were younger and 3rd or 4th grade when schoolwork projects became more like “parent” projects.
the most romantic thing my wife would say i have done… you better ask her.
my best quality…
I hope it’s my attitude. I try to be an upbeat, positive person. As they say, it’s not what happens to you, it’s how you deal with it that matters most.
I have always enjoyed… simple. I get the most enjoyment out of simple things...spending time with my family and friends, playing catch in the backyard or shooting hoops in the driveway.

growing up my parents instilled in me… hard work—if you have earned it, you will enjoy it much more than if it’s given to you. It's one thing you have total control over in your life.
I am most proud of… it has to be my kids. It’s so much fun to watch them grow up and become adults—seeing the little things you tried to instill in them are actually present.

something i hardly ever do but really enjoy… spending the day at the farm helping my brother. one of my favorite hobbies… shopping for cars, trucks, farm equipment. I’m always on the lookout for a great bargain. the ideal day for me would mean… a great workout in the morning followed by a deep muscle massage and an afternoon at leisure…on the deck, a beach, followed by happy hour with friends. my biggest pet peeve… people whose urge to talk overwhelms their ability to listen and understand.
the best parenting advice i have ever received… your kids grow up fast so always try to be there for them. You never know when they will most need your support.
if my wife could throw one thing of mine away it would be… the piles in my office. the three words my kids would use to best describe me… there, wisdom, patient the best advice for a couple embarking on the empty nest… enjoy it! We are having a blast. At first, it’s a little tough because it so quiet. You miss the noise and activity but as soon as you realize your schedule is your own again, it’s pretty cool. You do need a few good conversations with your spouse…you spent so many years raising your family that you may not realize your spouse’s or even your own ideas for the future may have changed.

your kids grow up fast so always try to be there for them






 rialee photography
tiny sprout portraits
countryside photography
skyloft photography
skyloft photography
delaine kimberly photography
countryside photography
rialee photography
tiny sprout portraits
countryside photography
skyloft photography
skyloft photography
delaine kimberly photography
countryside photography



 christopher haman photography
christopher haman photography

Youare often referred to as a birthmother, a title you have with you always though it may not be seen by most people in your life. This title names you as a woman who gave birth to a child and then made an adoption plan for that child, but it does not fully describe your role in our child’s life. To me, you are the first mother of our child.
After becoming pregnant, you made the deliberate decision to bring this child into the world when it may
have been easier, in some ways, to end your pregnancy through abortion. You withstood the difficulties this pregnancy could cause, including judgment from your family and friends, potential medical complications and the emotional battle being fought within you. Through the scariest time of your life, you nurtured, protected, loved and bonded with the baby inside you. You did all the things a mother does for her child even during the time you were most vulnerable. When the day of delivery came, you used all your love and strength to do what you saw was best for your child.
I have often heard the saying ‘things happen for a reason’ and it could easily be applied to our lives. One could say that “my husband and I have infertility issues because God knew I was meant to be the mother of your child.” I have no doubt that God is all-knowing and He knew I would be your child’s mother but I do not believe God made us unable to have children for this to happen. As with any difficulty in our lives, He was there and helped me to deal with our infertility issues. By placing my total trust in Him and His will for my life, He brought me to a fuller and richer understanding of love and compassion.


The paths of our life journeys crossed when I needed you and you needed me. What an amazing realization that God calls us to depend on others in our community of faith, especially when our culture strives for independence and self-actualization. How humbling it is to have to trust and depend on someone else with the biggest decision of our lives! I gave up my plan for my life and started ‘waiting to be chosen’ to be a mother. You placed your complete trust in me, a total stranger, to raise the child whom you love with your entire being. Little did we know God was beside both of us through it all, gently leading us to each other in our time of need.
Our relationship can be hard to explain and even harder to understand, especially to those who are not familiar with an open adoption. We share the very precious role of being a mother to the same child. Our child will know the unconditional love not just from the mom who is raising her but also from the mom who gave her the gift of life. I have a deep respect and unconditional love for you. You are my child’s first mother and without you and the choices you made, I would not be a mom. You truly inspire me to be the best mother I can be to our child, following your example of self-sacrifice, trust and love.
With love, Your Child’s Mom
This section is dedicated to capturing your parent thoughts. Want to share what’s on your mind? Submit your article idea to info@onthemindsofmoms.com along with a short bio for consideration in an upcoming issue.

Okay. We’re friends, right. I can be honest with you. I tried to spin this issue’s column with light-hearted humor and laughter. But, the more I write the heavier my heart. Our family is in the midst of a transition. We are thrilled, but…


Like the comedian & actor, Billy Crystal, once said, “Change is such hard work.” There’s no getting around it. Transitions are challenging. But, change is a part of living. If we don’t experience change, we can’t grow. And, if we aren’t growing, we certainly aren’t living. Try explaining this to a child. These creatures yearn for stability, structure, and a plan. I suppose we all do, really. There’s safety and a sense of power and control in knowing what to expect next.
That said, change broadens our horizons and can be exhilarating and exciting, even if it is exhausting and scary. Life’s transitions often generate opportunity and hope and elevate our courage...if we so choose.
This is the route we decided to take when sitting our children down to tell them that their worlds are about to change.
Last November, Governor-designate Jack Dalrymple appointed my husband, Drew, to be his Lieutenant. Drew was honored to be considered and proudly accepted. As a general rule in our house, it’s the big people who make the big decisions and little people follow their lead. But, none of us, no matter our age or rank, is immune to the effects of change. And, most of the time, if the big people are paying attention, we learn from watching the wee ones.
We were so eager to share this news with the kids--the evening before the official announcement. Timing of this disclosure was carefully crafted. We sat down to dinner and Drew headlined what was about to happen: “So guys, you know that we have a new Governor. You remember Jack Dalrymple. Well, he gets to pick someone to be his Lieutenant Governor…and well, he asked Daddy to join his team as his Lieutenant.” SILENCE.
Drew: “So…whadya’ think about that?”
MORE SILENCE.
I think we were a little stunned by their reactions. I completely misread how they’d respond and underestimated the consequences this transition will bring to their pediatric lives.

Patrick [8] immediately declined to move to Bismarck with us--like it was an invitation. He was quite serious… and sad. His school buddies had already extended their home to him, and he decided it would be best if he just moved in with them.
I explained that we’re all in this together and together we’ll build new friendships and expand our experiences. We’ll find our way…together…to which Patrick replied through tears, “But, mommy, I’m afraid my old friends will forget why they even liked me in the first-place.”
Patrick crawled into bed later that night, still so sad about leaving everything he knows, and told Drew he thought he’d be ok, but “still should probably sign up for a session with the guidance counselor at school tomorrow.”
This child has a tender-heart. His impulse is to talk about this next phase while taking baby steps to acceptance.
Harper’s reaction brought levity to the situation. Even Patrick snorted through his tears. Trying to console her big brother, she patted Patrick on the back and with her cute lisp told him, “It’s ok, Pathwick. You be ahh-wight. And, you can come wif us. And, Quinny can come wif us, too. And I can come wif us…wight Daddy. Can I come wif us, too, Daddy? We awe doe-ing to move to the Fahgo-Dome wif Eh-mo and my best fwends, Zoe and Tookie Monstah. It is so gweat, Pathwick. You be ahh-wight.” Who knew that seeing Sesame Street Live at the Fargodome just weeks prior would have left such an impact? At 2 ½, this child was digesting transition the only way she knew how: with Elmo by her side.
Our oldest—a very resourceful child—Quinn tried to reassure her little brother [and herself ] by attempting to finagle a ride to and from school every day via…the state plane! This would mean, “We could go to the
same school and not have to leave our friends.” Quite a scheme for a fourth grader, but rest-assured fellow tax-payers: this is not in our plan!
Instead, we agreed to paint her new room yellow, her favorite color, “for her whole life.” Knowing that through this transition, she’d be surrounded in yellow somehow provided a sense of comfort and confidence. She’s on-board. Full-steam ahead…filled with yellow.

None of us—no matter how old or young—is immune to the effects of transitions.
Watching these little people process this transition shows us that we are all unique—no matter our age, experience or height. We hear, react to, process, and accept change in our own way. Ironically, appreciating our individuality enables us to tackle this transition as a team.

Time is a gift in many ways. Time allows us to digest transitions and offers a chance to shape a new plan. It absorbs the shock and settles us into acceptance of life’s transitions.
And, so with every passing day, the kids are more and more excited to look at homes on the internet. They can’t wait to try out the water park in Bismarck. They’re looking forward to connecting with new friends, and finding fun ways to stay in touch with old ones.

I understand how our kids are feeling. I’ve moved several times and know how this works. I am sick to leave all things familiar and comfortable: our family, our church family, the kids’ school & its staff, my friends, the gym, running groups, my hairdresser, our doctors and even the pharmacist, who has come to know us well!
Patrick, you’re not alone. Mommy [secretly] fears her Fargo friends will “forget why they liked me in the first-place,” too.
Yes, transitions are felt by everyone, no matter how tall or small you stand. They can be a painful process, but transitions always bring growth, enrichment and excitement.
Stay tuned…
Kathleen is a stay-at-home mom who serves on a number of community boards/committees, is active in her church, kids’ school, and politics and runs to sustain her own mental health! This Philadelphia native is married to a fourth generation North Dakotan, Drew, and proudly considers North Dakota her home. They have three children. Before becoming a mom, she was director for Bismarck’s Child Advocacy Center and was a speech writer. Kathleen received a BS from The Pennsylvania State University and completed her graduate studies at Temple University, in Philadelphia.


When the thought came to mind of writing an article about bra shopping, I figured the challenge was going to be interesting, exciting and a tad scary. I mean, is it really true that approximately 80% of women wear the wrong bra size? The only way for me to truly know meant busting out of my comfort zone and going on a fact finding mission to see if I could possibly be one of those 8 out of 10 gals wearing the wrong size.

As I sat down to write this article, I turned on my DVR to catch the last episode of the Rachael Ray Show and low and behold there was Clinton Kelly from TLC’s What Not to Wear. Call it fate [or an intervention!], he was sharing with the audience the top 5 bra issues women face:
1. Wearing a bra that is too small.
2. Using lingerie as a real bra.
3. Having too much padding.
4. Breasts are sitting too high.
5. Sagging just doesn’t cut it.
As I pondered his words, I recalled a statement from Tim Gunn with Marie Claire [fashion guru and host of Project Runway], saying how undergarments set the foundation


for all clothing, so without the right undergarments, it doesn’t matter how pretty your outfit looks. It is all about how it fits. Then I thought to myself, how come these men are giving us women advice on bras? Well, Clinton and Tim, time to get back to basics and find the right brazier for me and “the girls!”
I had to prepare myself for a day of being uncomfortable and nervous. I am definitely not one to partially undress in front of strangers, leaving them to mentally judge my uneven breasts caused by breastfeeding or that oh so ever pale, pasty, winter skin, but I had to do it. With cleanly shaven arm pits [which is a must ladies], a nude color bra, t-shirt and jeans, I started my day with the perfect cup of dark hot chocolate from Caribou Coffee and headed off to my first stop, Macy’s.
I entered the store and immediately found a very nice associate to assist me with a bra fitting. I took off my t-shirt and there I stood in my bra, nervous as could be, while she measured. What felt like hours, only took seconds. She didn’t mention my size, but with a look of determination turned and simply said “I’ll be right back,” as if it was a secret mission. Moments later there she was with two different bra styles in hand.



To backtrack a bit, before having a baby I would have sworn I was a solid 38C. Then during the 8th month of my first pregnancy I was fitted for a nursing bra at a local maternity store. At that time I was a 38D—I also used a bra extender for extra comfort. Now, 18 months after giving birth, there I stood in the dressing room to discover I was now a 36D. A perfect example of the roller coaster change our bodies can experience and why our bras should change too.


With my new size known, I started from scratch looking for an “everyday” bra. The first was a t-shirt style bra, which is commonly associated with smooth, invisible seams that look great under; you guessed it…a t-shirt.

I wore a t-shirt that day, to make sure the bras I tried looked great under my shirt and wouldn’t show the excess back fat and underarm flab I happen to be sporting right now. I started the day anticipating that getting fitted was going to be the toughest part, but I
My journey continued as I ventured over to Victoria’s Secret. I once again started with the measurement process to compare my size at Macy’s and it was exactly the same, a 36D. The associate brought me a wide variety of 5 different types of bras and I tried them all.
avoid wearing your bra for two consecutive days your body exudes heat and heat makes the lycra in the bra stretch when it is warm wearing your bra for more than one day in a row will cause it to deteriorate faster lycra needs at least 24 hours to cool off—so alternating bras each day will go a long way towards good bra care
was wrong. It was finding the perfect bra! I realized bra shopping is like finding the perfect jeans. It takes trying on a lot of different styles and brands before you know you found the right one.
After trying on different brands at Macy’s—Olga, Maidenform, Vanity Fair and Calvin Klein—I discovered Maidenform was the best option for me. They have a wide variety of styles and colors/patterns to choose from. Their softness, smooth fit and cup coverage was perfect for what I needed.
I absolutely fell in love with the smooth, ultra comfortable Incredible by Victoria Secret Demi Bra. The band was smooth, form fitting and extremely comfortable. According to the associate at VS, the band of any bra should be the primary support of your breasts, where the straps should just be there for backup. I was sold and could have purchased it in every color and pattern.
If Macy’s and Victoria’s Secret aren’t quite the places for you, I also made a stop at Lane Bryant, where they carry sizes 38C to 44H in-store and sizes 36C to 48DDD online. Other options to consider are Kohl’s, JCPenney, or Herbeger’s. And for you soon to be mommies, in the market for maternity or nursing bra, definitely try Mommy’s Maternity and Target. Just know there is something out there for all of us.
A few helpful hints I found along the way:
• Make sure when you are trying on bras that you look at the front, back and side views to determine if it truly fits.



• Put your arms down next to your sides and look in the mirror. Where do your breasts sit? They should sit halfway between your shoulders and elbows. Your breasts in the right position can make you look 10 pounds lighter.

• If you are not sure how your bra looks with the outfit you happen to be wearing the day you’re out bra shopping, check the stores return policy first, then take it home. Try the bras on with many different types of shirts, dresses, tanks, etc. to make sure you will be happy with your purchase. I know committing to a really good bra purchase can be expensive, but the trade-off of feeling and looking better is worth every penny.
With the every so changing female body that we are blessed to have, our bodies are constantly evolving
years!
due to pregnancy, weight gain or loss, our monthly cycle, illness and just simply with age. It’s inevitable our breasts are bound to be impacted in some way or another. But times have changed and bras have come a long way from the “over-the-should-bolder-holder” title. Getting the support and care necessary for “the girls” is out there…it’s just going to take time and patience to find it. Now, you know your mission…ditch the unsightly back roll, uncomfortable shoulder indents, bursting breast bulge or tomboy chest, get fitted and find that bra!
Now that you spent the time and money to find that perfect new bra, how do you take care of it and make it last? For the sake of time, many ladies will toss their bra in the washer and dryer, without knowing the wear and tear one wash cycle can have on a bra. Yes, hand washing and line-drying your bras is best, but let’s be realistic, time is a precious thing so here are a few tips to clean your favorite bras without the overwhelming hand wash, line dry theory:
1. Buy a mesh laundry garment bag at Target, Wal-Mart or K-Mart. Take the extra time to wash them on the delicate cycle in cold water and then hang or lay flat to dry.
2. No garment bag? Wash your bras solo. Hook the back clasps on the bra. It prevents twisting and makes it less likely for the underwire to get twisted in the bra. Consider tightening the shoulder straps as well so there is less to get tangled around another bra in the washing machine.
3. Set the rinse for cool or cold. This can make the elastic in the bra snap back to its original shape as long as the bra isn't too old.
4. There is never a good time to put a bra in the dryer. It can shrink and make it more likely for under-wire to poke through, no matter how reinforced the bra is. Before hanging it to dry leave the back clasped and reshape the cups to regain their form.
sources: wikipedia.com, marieclaire.com, rachael ray show, bra.lifetips.com

We’ve all done it. Time runs short and we take a safety shortcut, never meaning to harm anyone. Besides, the bad thing never happens—right?
Beth and Jeremy Nicholls from Devils Lake, N.D., tell the other side. Their little guy suffered a serious injury requiring specialized care from Sanford Children’s Hospital in Fargo. “Laine was so brave,” says Beth.
Today he’s the 2011 Children’s Miracle Network Hospitals Champion. The network supports 170 children’s hospitals throughout North America, including Sanford Children’s. Funds raised here stay here, helping kids you know.
For a week Laine stayed at Sanford Children’s Hospital where specialized wound care prevented infection. Beth worried hospitalization might scare Laine. The playroom, child life specialists and caring nurses—all made the difference. “He healed really well,” she says.
Beth and Jeremy needed healing, too. “We felt so guilty,” she says. “Why was I with the horses when I should have been home with the kids? Why didn’t we put that gun away? So many whys.” Family support and visits with Sanford Children’s staff helped.
“And yes, we definitely made changes in our home as far as gun safety,” she says.
the beauty of routine
Laine needed months of outpatient wound care including frequent trips to Fargo for dressing changes. The process—especially the tape removal—could’ve been painful, but wasn’t.
so what happened?
Sept. 26, 2010—Beth left home that morning to load her horses for a day of barrel racing. Jeremy went out to do chores while 14-year-old Tanner watched 3-year-old Laine.
Four miles from home, Beth got a call from Tanner. She heard Laine screaming and knew something terrible had happened. A gun had accidentally fired.
“Tanner did everything right, including calling the ambulance in Devils Lake,” says Beth.
The 12-gauge shotgun used for bird-hunting had been leaning against the corner by the door. When it fell, Laine was just 15 feet away.
quick trip to high-level care
The shot tore through Laine’s right hip, leaving one pellet behind. The wound was extensive, prompting the Devils Lake ER to call Sanford LifeFlight.
Beth accompanied Laine on the airlift to Fargo, thankful for a highly trained flight team.
At Sanford Medical Center, Dr. Gary Kubalak, trauma surgeon, removed the pellet and set the stage for an excellent recovery.
“We had a routine,” says Beth. “Laine would pull his little wagon into surgery, a child life specialist and I would go with him, she’d place the nitrous oxide mask on his face and he’d fall asleep. He’d wake up in his hospital room, have crackers and apple juice, then head to the playroom. He loved that.”
Children’s Miracle Network donations support the “awesome extras” the Nicholls appreciated—the child life specialists, the nitrous oxide program, the playroom and more.
And champion Laine? He jumps and plays like any 3-year-old. “Even ordinary things mean a lot after going through something like this,” Beth says. “We’re so grateful.”
For more on Laine and how to donate to Children's Miracle Network, visit foundation.sanfordhealth.org.
 photo: otmom | sanford health
photo: otmom | sanford health
 story by | patricia carlson
story by | patricia carlson
She could see the crowd through the tiny window on the plane and a cluster of eager faces, holding posters, clutching balloons and waving American flags on a hot summer afternoon underneath a vibrant, baby blue sky. When the wheels screeched their welcome, people whooped with delight—“They’re home!” As the plane slowed to a stop, she craned her neck, hoping to get a sneak peak. “They’re out there somewhere,” she remembers thinking. She stands, smooths her uniform, and starts walking. Her heart races as her khaki boots grip each step on the way down and her legs wobble as she reaches the edge of the crowd. Then, as she spots them, all the chaos around her—the hugs, tears, cheers and kisses—blurs into slow-motion, like a special effect in a movie. She drops to her knees, reaches out and throws her arms around them breaking into a joyous smile of relief and comfort. She is home.
 photos: rialee photography | ria czichotzki
photos: rialee photography | ria czichotzki
rotc
Anna Wittrock grew up the youngest of 14 children to Lester and Verna Grafstrom in Salol, Minnesota, just outside of Roseau. She was so young compared to some of her siblings that even though they grew up in the same house, they often weren’t there at the same time. “When her older brothers came home from college, she was trying to figure out who those big guys were,” her mom, Verna, says with a chuckle.
It was a simple life on a 1,000-acre farm. The highlight of Anna’s day would be catching a ride into town with an older brother or sister to check out some of the sporting events, after she got her chores done. “Of course there was always some discussion of who got to stay in the house and clean and who had to go out and feed the calves,” says Thora Bunke, Anna’s next-oldest sister and best friend.
But simple doesn’t mean it was boring. “Anna was a go-getter from the start,” says her mom. Anna played volleyball, basketball and softball and sang in the choir during high school and those two interests eventually lead her to Concordia College to pursue a degree in education. During her freshman year in the fall of 1998, Anna joined the start-up women’s hockey team. “I had never played hockey before on an organized team but I could skate. I’m from Roseau, after all,” she says laughing. “My dad used to flood a rink for us in the backyard when we were little.”
One day after practice, Anna noticed an advertisement on the wall at the gym. It was a recruitment flyer for the Army Reserve Officer Training Corps [ROTC] program.
“I thought I’d be good at it,” Anna says, adding, “I like being a leader and I’m competitive. I wanted a challenge and I wanted to take the physical fitness test. I wanted to beat the boys.” Anna dialed the number listed on the flyer that day. “I was the easiest sell ever for that recruiter,” she says, grinning. And so, in 2000, Anna enlisted in the National Guard.
After completing basic training over the summer, Anna returned to Concordia to continue the ROTC program and play hockey. But something was about to happen that would make her question the direction her life was headed.
Anna was driving to an ROTC class when she heard the unthinkable news: planes had crashed into the World Trade Center in New York City and thousands of people had died as the Twin Towers crumbled in duress. When Anna arrived at the class, she found out terrorists were behind the attack. And she knew that as a member of the United States military she would be called upon to respond.
“I figured we’d do something,” she says stoically. “But I didn’t know to what degree the National Guard would be involved. The National Guard hadn’t deployed as often as it does now before 9/11 happened.”
The terror attacks, along with the announcement of an impending war with Iraq, made Anna question her decision to join the military for the first time. “I didn’t know if I wanted to continue or if I should quit. I think deep down I wanted to continue with the military, but I just wasn’t sure. I needed some guidance,” she remembers thinking. A phone call home gave Anna her answer.
Anna’s father never deterred her from enlisting, but she always knew he didn’t believe the military was the right place for a woman. However, when she conveyed her concerns, her dad told her, “You can’t quit now. You’ve put too much into it.” And he was right.
Anna decided to stick with being a soldier although she still wasn’t sure if it was the career she wanted. In the meantime, she and college sweetheart Cody, embarked on building a life together. Four months after graduating from Concordia in 2002, the couple married and moved to South Dakota for Cody’s job. Anna got a job at a bank but quickly realized it wasn’t for her. Cody puts it another way, “She hated it!”
Around that time, a full-time, temporary position as a training officer opened up with the North Dakota National Guard in Valley City. Despite the distance between Valley City and South Dakota, Anna didn’t need much convincing that taking the job and diving full-time into the military world was the right move. With Cody’s full support, Anna moved to Moorhead, lived with her sister Thora, and drove to Valley City to work for what was then known as Headquarters and
“It was awesome,” Anna says with a huge smile, remembering the summer day she stepped off that plane, dropped to her knees and enveloped her family in her arms



Headquarters Company [HHC], 141st Engineer Combat Battalion. She and Cody saw each other on weekends. “I guess one thing we’ve learned in this relationship is that absence makes the heart grow fonder,” Cody says. “I’ve always chased her and I still will.”
iraq
November 2003. Anna and Cody had been married for 14 months when she got her mobilization orders; she would be heading to the place she had initially feared—the war in Iraq. At the time, Anna says she remembers feeling a lot of anxiety because so much was unknown about warfare in the middle-east. “You just didn’t know what was out there,” she says. “We deployed in support of Operation Iraqi Freedom II and there wasn’t a lot of established tactics, techniques and procedures to combat insurgency.”
Anna also had Cody on her mind. How could she leave him again—this time going to a dangerous war zone—after already living apart from him for the first six months of their marriage? Clearly she didn’t have a choice, but that didn’t make the situation any easier for either of them.
In January 2004, Anna left Cody behind and flew to Iraq to begin her mission. She turned 25 while there and also was a new lieutenant, continuing to climb the National Guard ranks. Anna headed a human resources department filled with 10 other female soldiers. “Being a woman I couldn’t be with an engineering line company, so that was hard,” she says. “But being in charge of that many women was a good learning experience.” Even though Anna’s role during the war may have been administrative, like anyone exposed to the horrors of war, she experienced great grief that still haunts her today. “We lost four soldiers while I was there,” she says quietly. “For me, sometimes it’s like I have to convince myself that I really was there. I don’t know if I block it out on purpose, or maybe it’s because my immediate focus is on my boys and my family right now.”
Anna returned home in February 2005, but one thing had changed—she and Cody were living in Moorhead, together. While she was deployed, Cody embarked on a new career and eventually started his own construction business. Luckily, the move put them closer to

immediate family; Thora lived in town, as did two of Anna’s other siblings. Anna and Cody were also ready to start a family. First came Cole, who is now 5; Jude, 3, followed a year and a half later. A natural born leader, Anna now found herself in charge of something entirely new—two precious and precocious boys. And just like her role in the military, it was a perfect fit. “She gets the boys into a lot of activities that I never even think about,” her husband says. “She's creative with their rooms and always has the favorite birthday or Christmas present for the boys.”
As Anna’s home life was changing, so too, was her career in the Guard. She continued to work for the National Guard, only by this time, she had earned a permanent full-time position as the Officer Strength Manager in Fargo, ND.
Coincidentally, the promotion put her back in touch with her college hockey coach, Major Debra Lien, who was also working full-time with the ND National Guard as the Officer in Charge for the 231st Brigade Support Battalion in Valley City. “I knew that she would be a hard worker, she had demonstrated the willingness to
learn and also had the capabilities to be a good officer. Anna is a calm leader,” Maj. Lien says. “She never really gets too excited or anxious. She has tremendous people skills and communications skills. I believe that soldiers find her easy to approach with a problem and she is able to provide them the guidance that they are seeking.”
Anna supervises a group of full-time soldiers and hundreds of other soldiers who serve in a traditional weekend and two-weeks-a-year capacity. It’s a fulfilling career, something this natural born leader not only takes pride in but is also good at. “People in the community thank you for your service,” Anna says. “It’s humbling.”
sacrifice
It’s also a huge sacrifice. Five years after Anna returned home from war, she got another mobilization call for a peacekeeping mission in Kosovo. If she thought leaving her husband behind the first time was difficult, learning she wouldn’t see her two boys for a year was devastating.
She and Cody prepared for another separation, this time having to explain to their toddler boys, ages three and two at the time, that their mom was leaving home for a

year. “Telling them was hard, I knew it was going to be hard,” Anna says. “We bought a map and showed them where Kosovo was. They didn’t care, they couldn’t. They didn’t really have a concept of time at that age.” But Anna did and she knew being away from her family was going to be the hardest thing she’d ever done, maybe even as hard as heading to war.
Anna will never forget the day she left. The family of four climbed into the car for the short drive over to her sister Thora’s where Cole and Jude loved to play with their three cousins. As Anna prepared to leave, she called her boys over. “Ok, guys, I’m going,” she said in between hugs and kisses, careful not to let them see her cry. “I’ll be gone a long time. But I love you and I’ll see you on the computer.” The boys, eager to play and unable to understand the implication behind their mom’s words, bounded away—“Ok, love ya mom!,” they shouted. Anna walked back to the car and settled into the passenger seat next to Cody. And there, impeccably dressed in her uniform, a soldier cried. “I broke down,” she says. “Just broke down.”
It was a painful moment for her sister, too. “There she stood, about to leave these two little boys for one full year,” Thora says. “Heartbreaking. In the back of my mind, I'm thinking about the birthday parties she
was going to miss, the holiday celebrations, missing her boys and the funny things kids say every day. How strong she must be!”
kosovo
Anna’s deployment to Kosovo was unlike her mission in Iraq in almost every way. “It was peacekeeping mission,” Anna says, adding, “I didn’t feel unsafe at all.” By this time, she was a Battle Captain and was in charge of tracking current operations for the 141st Maneuver Enhanced Brigade. Anna worked with soldiers from Ukraine, Poland, Greece and Turkey in a joint operations center.
Meanwhile, life was anything but boring for Cody. The dad of two young boys was now responsible for running the household. “I can't say the house was super clean but it was picked up. Laundry was done, bedding would get washed and beds got made,” he says.
Luckily, Anna and Cody’s families stepped in to take some of the pressure off of Cody. Their niece, Kim Grafstrom, moved into the spare bedroom and cared for the boys while in between going to college. Thora and another of Anna’s sisters, Renae, were there in a pinch too, taking the kids to church, picking them up from daycare or cooking those nutritious dinners Cody sometimes needed help preparing.
Even though she was a continent away, the sacrifice Anna’s extended family was making did not go unnoticed. “I can’t emphasize enough the support system we had. Our whole family served, not just me.”
Technology had changed for the better since Anna’s first deployment to Iraq. She was able to communicate daily with her family. “It was very good for the boys to be able to see that their mom was still alive somewhere,” says Cody. “They would always tell people that their mom was in Kosovo but had no idea where it was at.” Still, a virtual hug couldn’t replace the real thing and when the holidays rolled around, times got tough. “When they’re celebrating Christmas, or other events, you can’t help but be bummed,” Anna says. “But you can’t let yourself get down or feel sorry for yourself. It doesn’t make things better. Besides, everyone’s in same situation.”

If you ask Anna, she’ll tell you there is no feeling quite like that of your child’s arms wrapped around you in
a warm, welcoming hug. And on July 24, 2010, after a yearlong deployment, she got to feel that sensation again.
“It was awesome,” Anna says with a huge smile, remembering the summer day she stepped off that plane, dropped to her knees and enveloped her family in her arms. “My heart was racing. I had butterflies. I couldn’t get to the boys and Cody fast enough.”
Since Anna’s return, the Wittrock’s have settled into an easy, familiar routine. Anna has resumed her ‘mommy’ duties and Cody is happy to be ‘just a dad.’ To the boys, Anna’s deployment is a forgotten memory, but she knows that one day her children will realize what her uniform means. For one, it stands for courage, honor and service and it has opened doors to experiences and travels a small town girl could only dream of. In fact, Anna is one of less than one percent of people in the nation who serves in uniform, something that she acknowledges is both impressive and sad. “When I heard that, I couldn’t believe it,” she says. “It’s an honor to serve.”
Anna’s camouflage is also a constant reminder of the tug-of-war the military will play with her family and



the sacrifice she’s made. She knows it was, and is, the right choice for her and her family and says she would even encourage her sons to enlist when they get older. Perhaps most important to Anna though, is that we remember the men and women who paved the way for soldiers like her and helped make our country what it is today. “The thing that stands out for me is the civic duty behind serving. When I’m at a parade and I see the veterans from the VFW guys walking by carrying the flag—some of them can hardly walk—they’re still out there serving,” she says tears springing to her eyes. “It’s an emotional thing to see and I tell my boys, ‘You respect them for what they did for you and respect the flag and all it stands for.’”
Well, Anna, we respect you and admire your commitment to serve our country. And we’re glad that no matter where the military takes you, you will always have a place to call home. It’s a familiar spot that’s warm and cozy, filled with smiles and kisses—the arms of your loving family.
 photo: thuen design | scott thuen
photo: thuen design | scott thuen
 story by | sheri kleinsasser stockmoe
story by | sheri kleinsasser stockmoe
They start out cooing and babbling. Then come a few words that melt your heart. Next those words are stringed together to form sentences and soon the questions start! At first they are easy questions like “what’s that?” But as he grows the questions evolve in complexity. The answers can be as simple as recalling seventh grade science. OK, maybe simple isn’t the right word, but the answers consist of straight up facts; black and white details. And then there are the HARD questions. The questions about life with answers that can make any mama shake in her UGGs, stammer and reply…say what?
So,your wee one can’t talk yet, but being prego or having a new baby can prompt some interesting questions from a curious sibling, niece, nephew or stranger about the miracle of life. I remember being about seven-months pregnant, chatting with my sister in-law as my 5-year-old twin nieces watched television. Out of the blue one of the girls turns to me and asks, “How’s that baby get out of your tummy?” I thought to myself, “Honey, you DO NOT want to know!”

Oh, the miracle of life. Isn’t it an amazing process? Yes, of course…if you’re talking to another adult! When a kiddo inquires about the details of the baby getting in or out, it can stop you in your tracks. You need to give an answer even if you would rather run out of the room. There isn’t one “right” answer, but here are some tips to help you answer appropriately:
• come again? Take a moment and ask for some clarification before you answer. A 4-year-old asking where babies come from may simply be wondering if your wee one came from Target or Wal-mart while a 11-year-old may not be satisfied with an answer as simple as “the hospital.”

• who’s yo mama? If the child asking is yours, and you understand their question, the next step is to answer as honestly as you can to satisfy their curiosity, again taking into account their age. If it is someone else’s child, feel free to tell them they need to ask their parent.
• have ya heard of the stork? Again, you want to be honest, but in terms the kiddo asking can understand. You also don’t want to scare the crap out of them! Keep it simple. As adults we tend to make things more complex than they sometimes need to be. Keep your answer simple, truthful and age appropriate. Your simple answer may do the trick, but be ready for follow-up questions.
four million babies are born in the US each year
Ourtots are observant. They notice EVERYTHING and tend to share their observations in what can be considered not exactly politically correct. But noticing differences in people and asking questions gives you the perfect teaching opportunity.

hey, look at that!
Have you experienced that mortifying moment in public when your tot asks you a question or points out a characteristic of another person that you worry will be taken as offensive? And usually these comments are made right in front of the other person and at a decibel that could be heard outside the store and across the parking lot! But the important thing isn’t the question or statement, it’s how you react! Your tot’s comments aren’t a reflection of prejudice in your family; he’s looking for facts and learning about his world. Shushing your tot and scurrying away implies that what he is noticing is “bad” or “wrong.” When differences are pointed out, you should answer in a matter-of-fact manner and promote embracing diversity and tolerance:

• why is he fat? Point out that people are different sizes and being different is OK. Explain how you are a different size compared to him.
• why is her skin brown? Let him know that people are born with different skin colors. Just like people have different hair and eye color.
• I don’t like how she talks. Tell him that we speak the way our families speak and not every family speaks the same way. Also point out that the way he speaks sounds different to that person too.
• what’s wrong with him? Children can be curious and even nervous about people with disabilities. First, help him rephrase his question, such as “are you wondering about her wheelchair?” This takes away any judgment that was in his original statement. Then you can answer his question, “sometimes people can’t walk because their muscles aren’t strong enough so her wheelchair helps her move.”
in 2008, 56% of US kiddos were White, 22% were Hispanic, 15% were Black, 4% were Asian and 5% were of other races
Death is a part of life, but talking to your preschooler about it can be very hard. A story on TV, the death of a pet or family member or the changing of the seasons could prompt questions about death. Regardless of why they are asking it’s important to answer questions and reassure them while being honest.
You want to provide your preschooler with comfort and coping skills, but when the discussion of death is prompted by the passing of a loved one, it can be especially

difficult as you deal with your own grief. Many of your answers to questions related to death will depend on your religious beliefs, but here are some general points to help you explain death to your preschooler:
• real meaning Kiddos up to the age of six have a hard time grasping the concept and permanence of death. There are many ways they can ask you about death. Regardless of how they ask, usually their underlying question is related to their own wellbeing. Even a question like, “Are you going to die?” isn’t necessarily about you. They may be concerned about being separated from you or who would take care of them. Ask your preschooler what he thinks about this. This gives him the opportunity to express what he really wants to know. Maybe he is worried about who would cook dinner. You can then reassure him that you would always make sure he is taken care of.
• watch your words It’s important you select your words carefully when explaining death to your preschooler. Avoid telling him the person or pet “went away” or “went to sleep” or that the family “lost” them. Your preschooler is very literal and these phrases could inadvertently make him afraid to go to sleep, be fearful each time someone leaves, or he could expect the one that “went away” to be coming back soon.
• be open Encourage your preschooler to talk and ask questions. Creating an open environment to share his feelings is important. Also, let him know that you can talk about the loved one that passed away. This can be very healing. Lastly, death is a difficult concept, so expect to get asked the same questions many times over.
a preschooler requires mom's attention once every four minutes or 210 times per day
Timefor you and the honey is sparse to say the least. So when you get a little time for “wink-wink-nudgenudge,” you take advantage of it. Right? The tide turns in a hurry if the heat of the moment is interrupted with a shy big kid asking “Mom, what are you doing?” at the foot of the bed…UH-OH!
Getting caught in the moment, whether by little eyes seeing or ears hearing, can be bit disturbing for everyone involved, but it doesn’t mean you have years of therapy in your future. If you get caught with your pants down [sorry, it was too easy] here are some pointers for talking with your peeping big kid:

• deep breath Don’t freak out! Your big kid walking in on you doesn’t mean he is mentally scared for life. Getting hysterical will only make matters worse.
• you saw what? You need to talk to your big kid about what they saw or heard. For younger kids, you probably just need to tell them you and your partner were hugging or wrestling and no one was getting hurt. For older kids, they know what you were doing and are probably grossed-out. It’s pretty universal that no one wants to ever really believe their parents have sex, let alone see it! For your big kid, odds are they are going to have some questions. So, start by asking him what he saw or what he thought he saw. Then you can answer his questions appropriately.
• the talk How you explain things really depends on the maturity level of your big kid and what you have discussed in the past about sex. You might not be ready to talk about this, but your big kid might be. A full blown birds and the bees talk might not be necessary, but if your big kid knows there was more than hugging going down, focus your talk on
the fact that you and your partner love each other rather than the hard details of having sex.
Many of you did some planning when it came to making those adorable kiddos, so consider a little advance planning to your mattress mambo sessions to ensure all uninvited guests stay that way. Step one, lock the door! Genius, right? Next, turn off the light and add a little music or turn on the TV. Ben Franklin was right on when he said, “An ounce of prevention is worth a pound of cure.”
Thetweener years can be tricky. You still have a child, but a budding adult is waiting in the wings. Increased self-consciousness is common and you never want to fuel any type of insecurity, so what do you do if your tweener asks you, “Am I fat?”
you have the right to remain silent
So, what do you say in that situation? “Mom, do you think I’m fat?” Well, don’t answer! A simple yes or no, regardless of your tweener’s body composition, isn’t

the right answer. You should put the question back on them [“What do you think?” or “How do you feel?” ] and determine why they are asking. How do they see themselves? If your tweener doesn’t have any unrealistic body image views, what should you do if the honest answer is yes? Well, time to take action and help your tweener make some healthy lifestyle changes with these tips:
• get the facts Help your tweener do some research on their healthy weight. Set an appointment with your physician and put together a plan incorporating healthy eating and physical activity.

• no tunnel vision Make sure you help your tweener keep things in perspective. Focusing only on the numbers on the scale isn’t healthy. Help your tweener focus on eating healthier and getting active. Remind them that what is inside is always the most important part of a person.
• be on board Make sure you are “all in” when it comes to being supportive of the healthy lifestyle changes your tweener is embracing. Make healthy food selections readily available and remove the temptations. Be supportive, but don’t nag and be an example. Make sure you are modeling healthy eating and activity habits. Also, be conscious of how you talk about your own body and respective weight. Talking critically about yourself could prompt your tweener to do the same.


Youwere no angel. You made some choices in your teen years you aren’t necessarily proud of, but can’t you rewrite history in an effort to make sure your teen follows your rules and makes positive choices regarding alcohol and drug use? So, did you ever do drugs?


do as I say, not as I do
Forever we have preached tell the truth, don’t lie, the truth is always easier. But what if your teen behavior was less than stellar? Do you have to tell the truth?
The important thing isn’t what YOU did years ago it’s about helping your teen make the right choices in the future. What’s a good mama to do…
• be honest If you didn’t use drugs in your teen years, your answer is easy, “big fat NO!!! And you shouldn’t either!” Now if you did, do you lie? And is it really a lie if you’re doing it for the good of your teen? You don’t want to encourage any bad behavior or give your teen something to throw back at you to justify their current behavior, but lying could come back to bite ya. You can be honest and say yes, but make it clear why it’s important they don’t make the same mistakes you did.
• just the facts Yes, you can be honest, but you don’t have to include all the dirty details of your teen escapades. “Yes, I did drink when I was in high school, but I wish I hadn’t because…”
• keep it going Never, ever turn away the opportunity to talk to your teen when he is looking for guidance. Can it be uncomfortable? Yes, but if he is welcoming your opinion, give it! Don’t preach, but rather have a discussion. Ask questions to determine what is prompting his questions of your teen days and help him realize the appropriate and healthy choices.
says sally says sally says sally says sally says sally says sally says sally says sally sally says sally says sally says sally says sally says sally says sally says sally says says sally says sally says sally says sally says sally says sally says sally says sally sally says sally says sally says sally says sally says sally says sally says sally says says sally says sally says sally says sally says sally says sally says sally says sally sally says sally says sally says sally says sally says sally says sally says sally says says sally says sally says sally says sally says sally says sally says
She is our quintessential, “do-it-all” mom and friend who reminds us to remember the woman behind the mom.
this...Mother’s Day 1999. My husband sends my four cute children into our bedroom to wake me up. I always think they are cute on Mother’s Day, probably because of the amazing appreciation I receive on that day. You know how it goes, well-behaved kids, lounging and anything you want is yours. I love it! So, mid-afternoon my husband says, “Everyone in the van, we have a surprise for Mommy.” Wow, my mind goes wild. I am thinking they are dropping me off at a spa, lunch at my favorite restaurant or could it be... Nordstrom’s shopping spree! I am down right giddy as I get into the van. Imagine my surprise when we pull up to the bike shop. Really! Did I even ask for a bike
and if so why? But there we were, my kids beaming. I put a smile on my face and went in to pick out a super sexy bike [with the child seat]. Oh Zen, thank you for the attitude!
Zen got me through that day. What or who is Zen? Back in my corporate days I listened to a speaker and while I am not sure of his name or the book he was selling, I do remember Zen. The lecture moved me to do some research on the teachings of Zen. Zen like life is hard to define, but its essence is in the experience and “moment to moment” awareness. We can start with an easy example. You sitting reading this magazine is the best use of your time today. Hopefully you are reading, learning, laughing and letting the nagging thoughts fade
out of your head. Yes you might have cleaning, laundry or email to catch up on, but right now On The Minds Of Moms is the perfect place to put your attention.

The idea of Zen is to believe that the best place to be is where you are right now in this moment. As a mother I know what you are feeling. You worry about what cannot be controlled. Your guilt gets in your way. If you are at work you worry about being with your kids. If you are home you worry about missing a big meeting. If you take time for yourself you feel selfish. Before you know it your day has been spent agonizing over what you have or have not done. This can derail you and the people around you. The essence of Zen is to eliminate fear, negativity, hate and bitterness in your life. It is an attitude and attitude is everything.

I challenge you to live in the moment. Don’t give up on your dreams and goals for the future but do enjoy the journey of reaching them. Make little moments special. If you are having friends over for lunch set the table and give them all of your attention. If you are going to have a glass of wine, pour it into your best crystal
glass and enjoy that quiet moment and every sip. If you are going to your children’s sporting event, enjoy the game and the fun they are having don’t worry about the next game. Use this concept with everything you do. Once you start relishing the little things, the big things become extra special.
Now, I did find the perfect bike that Mother’s Day. I can’t tell you the brand or the cost and I think it was red but I am not sure. However, I do remember how the adventure ended. My husband and I looked at our twins as we were paying for the sexy addition to the family and knew instantly. We asked where the restrooms were and thought, “why do accidents even come in twos!” It was Mother’s Day so my husband did the honors; cleaned the boys up and threw the Power Ranger undies in the trash while I sat in the van giggling with the other two. Lets face it poop is funny! Now we still talk about that day 12 years later and how much fun we had as a family.
Even with the crazy ending I wouldn’t change a thing.


Nobody can be un‑cheered with a balloon.—Winnie the Pooh



